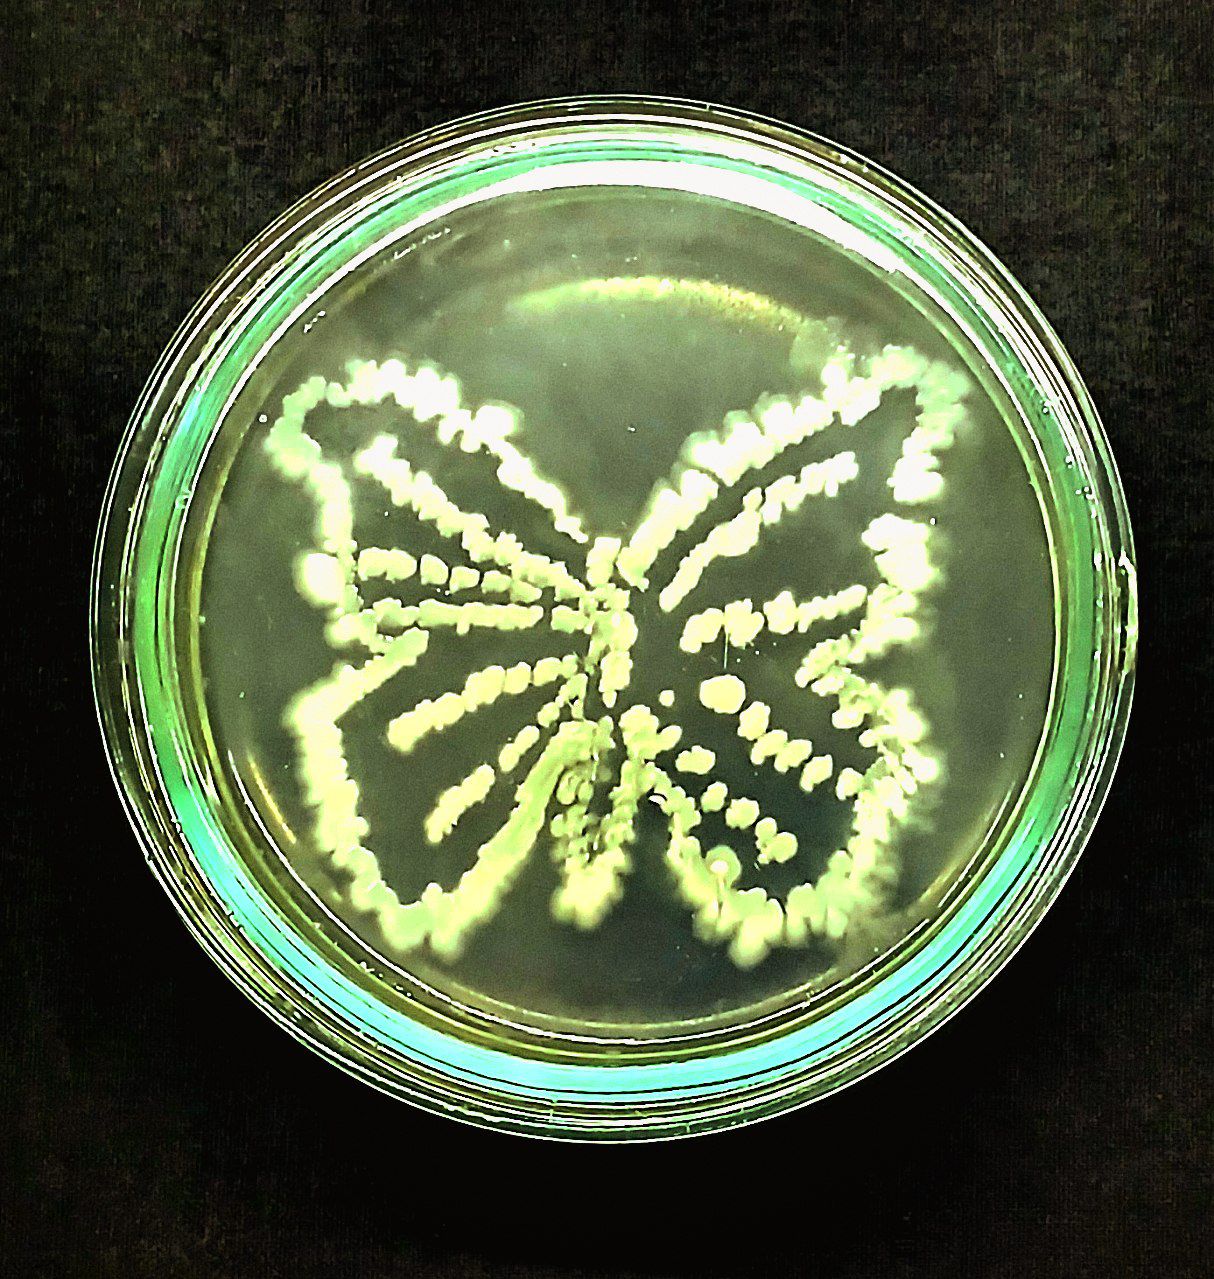
Not applicable (Image depicts bacterial culture, not a butterfly)

Not applicable (Image depicts bacterial culture, not a butterfly)
Image: Jasmina Rustamjonova (CC0)
Common NameNot applicable (Image depicts bacterial culture, not a butterfly)
Scientific NameN/A
FamilyN/A
SubfamilyN/A
Primary ColorsN/A
HabitatN/A
Geographic RangeN/A
Host PlantsN/A
Flight PeriodN/A
Lifecycle NotesN/A (This image does not show a Lepidopteran lifecycle.)
Identification TipsN/A (This is a microbiological culture, not a living insect. No entomological identification tips apply.)
Description
The image displays a petri dish containing a culture of bacteria (likely Salmonella spp. on Bismuth Sulfite agar) arranged in the shape of a butterfly. The bacterial colonies appear as yellowish-green growth against a darker agar background.